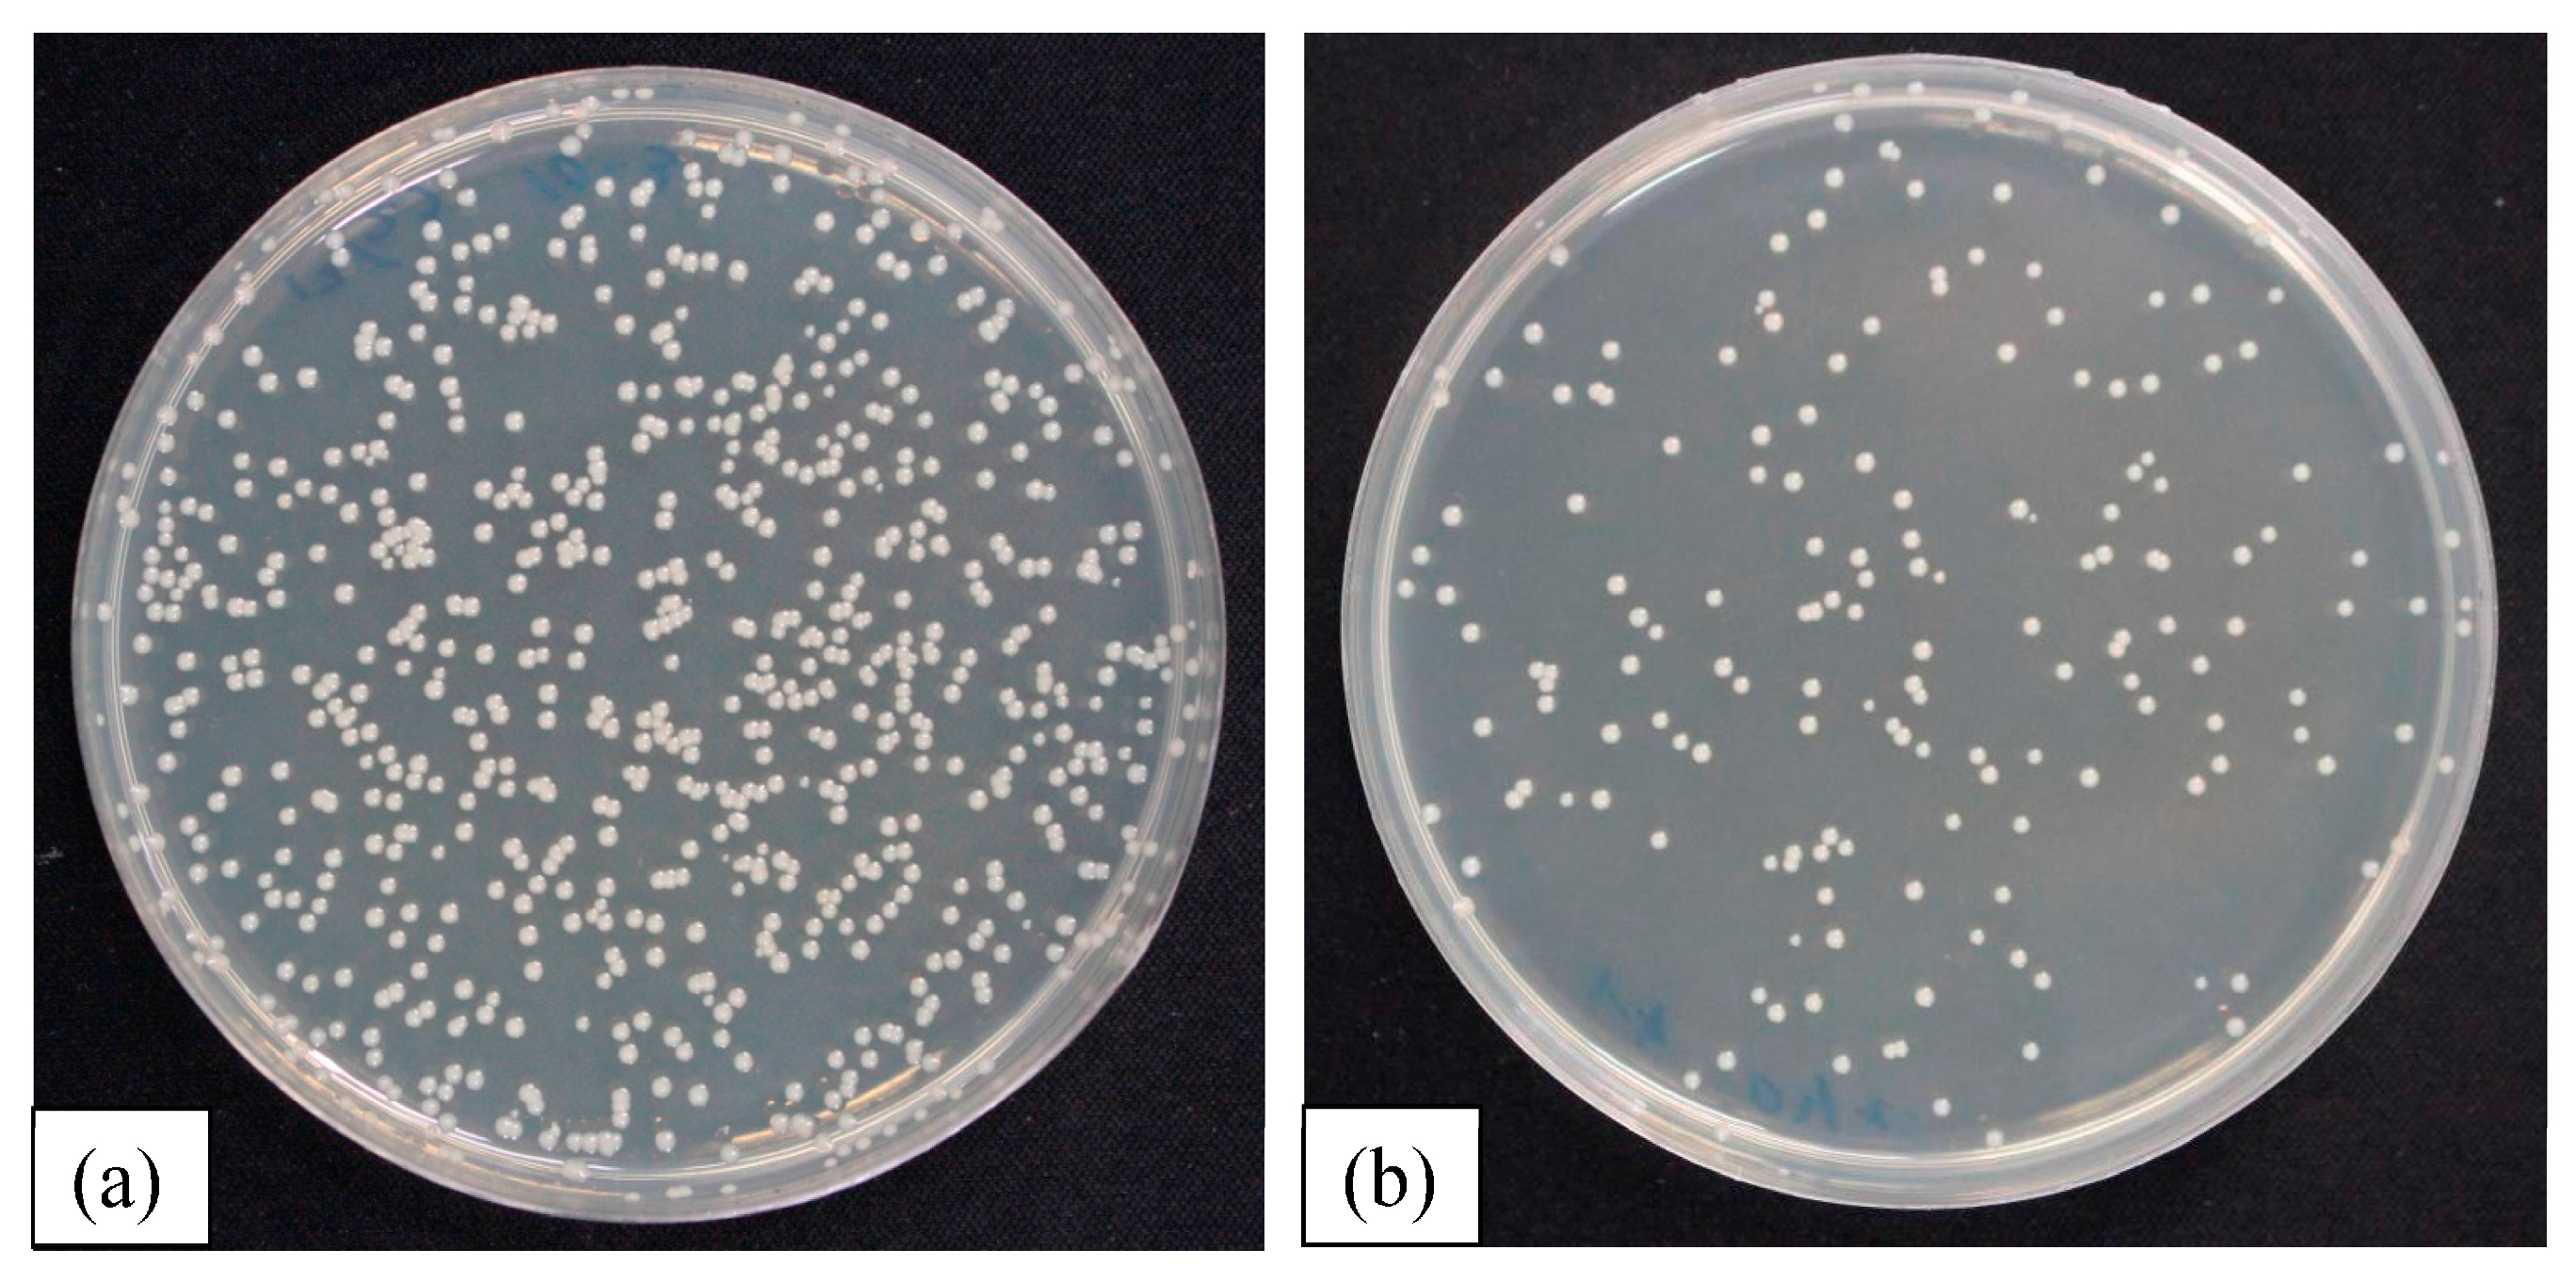
Materials 10 01189 g009

Antibacterial and Tribological Performance of Carbonitride Coatings Doped with W, Ti, Zr, or Cr Deposited on AISI 316L Stainless Steel
Abstract
:1. Introduction
2. Experimental Details
2.1. Analysis Equipment
2.2. Coatings
2.3. Hydrophilicity Test
2.4. Antimicrobial Test
2.5. Wear Test
3. Results and Discussion
3.1. Coatings
3.2. Hydrophilicity Test
3.3. Antimicrobial Test
3.4. Wear Test
4. Conclusions
Author Contributions
Conflicts of Interest
References
- Muzio, G.; Miola, M.; Perero, S.; Oraldi, M.; Maggiora, M.; Ferraris, S.; Vernè, E.; Festa, V.; Festa, F.; Canuto, R.A.; et al. Polypropylene prostheses coated with silver nanoclusters/silica coating obtained by sputtering: Biocompatibility and antibacterial properties. Surf. Coat. Technol. 2017, 319, 326–334. [Google Scholar] [CrossRef]
- Etiemble, A.; Der Loughian, C.; Apreutesei, M.; Langlois, C.; Cardinal, S.; Pelletier, J.M.; Pierson, J.-F.; Steyer, P. Innovative Zr-Cu-Ag thin film metallic glass deposed by magnetron PVD sputtering for antibacterial applications. J. Alloys Compd. 2017, 707, 155–161. [Google Scholar] [CrossRef]
- Groessner-Schreiber, B.; Herzog, M.; Hedderich, J.; Duck, A.; Hannig, M.; Griepentrog, M. Focal adhesion contact formation by fibroblasts cultured on surface-modified dental implants: An in vitro study. Clin. Oral Implants Res. 2006, 17, 736–745. [Google Scholar] [CrossRef] [PubMed]
- Groessner-Schreiber, B.; Hannig, M.; Dück, A.; Griepentrog, M.; Wenderoth, D.F. Do different implant surfaces exposed in the oral cavity of humans show different biofilm compositions and activities? Eur. J. Oral Sci. 2004, 112, 516–522. [Google Scholar] [CrossRef] [PubMed]
- Huang, H.L.; Chang, Y.Y.; Lai, M.C.; Lin, C.R.; Lai, C.H.; Shieh, T.M. Antibacterial TaN-Ag coatings on titanium dental implants. Surf. Coat. Technol. 2010, 205, 1636–1641. [Google Scholar] [CrossRef]
- Nuñez, J.A.P.; Salapare, H.S.; Villamayor, M.M.S.; Siringan, M.A.T.; Ramos, H.J. Enhanced adsorption of Ag+ on triethanolamine modified titanate nanotubes. Surf. Interfaces 2017, 8, 28–35. [Google Scholar] [CrossRef]
- Marciano, F.R.; Bonetti, L.F.; Mangolin, J.F.; Da-Silva, N.S.; Corat, E.J.; Trava-Airoldi, V.J. Investigation into the antibacterial property and bacterial adhesion of diamond-like carbon films. Vacuum 2011, 85, 662–666. [Google Scholar] [CrossRef]
- Zhou, H.; Xu, L.; Ogino, A.; Nagatsu, M. Investigation into the antibacterial property of carbon films. Diam. Relat. Mater. 2008, 17, 1416–1419. [Google Scholar] [CrossRef]
- Jeyachandran, Y.L.; Venkatachalam, S.; Karunagaran, B.; Narayandass, S.K.; Mangalaraj, D.; Bao, C.Y.; Zhang, C.L. Enhanced ionodetection by using polyethyleneimine as an insulator material. Mater. Sci. Eng. C 2007, 27, 35–41. [Google Scholar] [CrossRef]
- Hilbert, L.R.; Bagge-Ravn, D.; Kold, J.; Gram, L. Influence of surface roughness of stainless steel on microbial adhesion and corrosion resistance. Int. Biodeterior. Biodegrad. 2003, 52, 175–185. [Google Scholar] [CrossRef]
- Marciano, F.R.; Bonetti, L.F.; Da-Silva, N.S.; Corat, E.J.; Trava-Airoldi, V.J. Wettability and antibacterial activity of modified diamond-like carbon films. Appl. Surf. Sci. 2009, 255, 8377–8382. [Google Scholar] [CrossRef]
- Ishihara, M.; Kosaka, T.; Nakamura, T.; Tsugawa, K.; Hasegawa, M.; Kokai, F.; Koga, Y. Antibacterial activity of DLC and Ag–DLC films produced by PECVD technique. Diam. Relat. Mater. 2006, 15, 1010–1014. [Google Scholar]
- Liu, A.Y.; Cohen, M.L. Prediction of new low compressibility solids. Science 1989, 245, 841–842. [Google Scholar] [CrossRef] [PubMed]
- Wäsche, R.; Hartelt, M.; Springborn, U.; Bewilogua, K.; Keunecke, M. Wear of carbon nitride coatings under oscillating sliding conditions. Wear 2010, 269, 816–825. [Google Scholar] [CrossRef]
- Takadoum, J.; Rauch, J.Y.; Cattenot, J.M.; Martin, N. Comparative study of mechanical and tribological properties of CN and x DLC films deposited by PECVD technique. Surf. Coat. Technol. 2003, 174, 427–433. [Google Scholar] [CrossRef]
- Park, Y.S.; Myung, H.S.; Han, J.G. Characterization of CNx thin films prepared by close field unbalanced magnetron sputtering. Thin Solid Films 2005, 475, 298–302. [Google Scholar] [CrossRef]
- Camero, M.; Buijnsters, J.G.; Gómez-Aleixandre, C.; Gago, R.; Caretti, I.; Jiménez, I. The effect of nitrogen incorporation on the bonding structure of hydrogenated carbon nitride films. J. Appl. Phys. 2007, 101, 063515. [Google Scholar] [CrossRef]
- Zhang, S.; Fu, Y.; Du, H.; Zeng, X.T.; Liu, Y.C. Magnetron sputtering of nanocomposite (Ti,Cr)CN/DLC coatings. Surf. Coat. Technol. 2002, 162, 42–48. [Google Scholar] [CrossRef]
- Hsu, C. Effects of Tungsten Addition on Mechanical and Tribological Properties of Carbon Nitride Prepared by DC Magnetron Sputtering. Master’s Thesis, National Cheng Kung University, Tainan, Taiwan, 2014. [Google Scholar]
- Wu, X. Effect of Chromium Addition on Tribological Properties and Corrosion Resistance of Carbon Nitride Prepared by DC Magnetron Sputtering. Master’s Thesis, National Cheng Kung University, Tainan, Taiwan, 2015. [Google Scholar]
- Yeh, K. Effect of Titanium Addition on Mechanical and Tribological Properties of Carbon Nitride (a-CNx) Prepared by DC Magnetron Sputtering. Master’s Thesis, National Cheng Kung University, Tainan, Taiwan, 2016. [Google Scholar]
- Lai, C.-H.; Chang, Y.-Y.; Huang, H.-L.; Kao, H.-Y. Characterization and antibacterial performance of ZrCN/amorphous carbon coatings deposited on titanium implants. Thin Solid Films 2011, 520, 1525–1531. [Google Scholar] [CrossRef]
- Huang, H.-L.; Chang, Y.-Y.; Liu, J.-X.; Tsai, M.-T.; Lai, C.-H. Antibacterial activity and cell compatibility of TiZrN, TiZrCN, and TiZr-amorphous carbon coatings. Thin Solid Films 2015, 596, 111–117. [Google Scholar] [CrossRef]
- Hosokawa, A.; Shimamura, K.; Ueda, T. Cutting characteristics of PVD-coated tools deposited by unbalanced magnetron sputtering method. CIRP Ann. Manuf. Technol. 2012, 61, 95–98. [Google Scholar] [CrossRef]
- Kuptsov, K.A.; Kiryukhantsev-Korneev, P.V.; Sheveyko, A.N.; Shtansky, D.V. Effect of laser shock peening on microstructure, mechanical properties and corrosion behavior of interstitial free steel. Surf. Coat. Technol. 2013, 216, 273–281. [Google Scholar] [CrossRef]
- Polcara, T.; Vitu, T.; Cvrcek, L.; Vyskocil, J.; Cavaleiro, A. Effects of carbon content on the high temperature friction and wear of chromium carbonitride coatings. Tribol. Int. 2010, 43, 1228–1233. [Google Scholar] [CrossRef]
- Cotrut, C.; Braic, V.; Balaceanu, M.; Titorencu, I.; Braic, M.; Parau, A.C. Corrosion resistance, mechanical properties and biocompatibility of Hf-containing ZrCN coatings. Thin Solid Films 2013, 538, 48–55. [Google Scholar] [CrossRef]
- Wang, L.; Zhao, X.; Ding, M.H.; Zheng, H.; Zhang, H.S.; Zhang, B.; Li, X.Q.; Wu, G.Y. Surface modification of biomedical AISI 316L stainless steel with zirconium carbonitride coatings. Appl. Surf. Sci. 2015, 340, 113–119. [Google Scholar] [CrossRef]
- Grigore, E.; Ruset, C.; Li, X.; Dong, H. Zirconium carbonitride films deposited by combined magnetron sputtering and ion implantation (CMSII). Surf. Coat. Technol. 2010, 204, 1889–1892. [Google Scholar] [CrossRef]
- Yao, S.H.; Su, Y.L.; Kao, W.H.; Cheng, K.W. Wear behavior of DC unbalanced magnetron sputter deposited ZrCN films. Mater. Lett. 2005, 59, 3230–3233. [Google Scholar] [CrossRef]
- Ospina, R.; Escobar, D.; Restrepo-Parra, E.; Arango, P.J.; Jurado, J.F. Mechanical and tribological behavior of W/WCN bilayers grown by pulsed vacuum arc discharge. Tribol. Int. 2013, 62, 124–129. [Google Scholar] [CrossRef]
- Chen, X.; Peng, Z.; Fu, Z.; Wu, S.; Yue, W.; Wang, C. Microstructural, mechanical and tribological properties of tungsten-gradually doped diamond-like carbon films with functionally graded interlayers. Surf. Coat. Technol. 2011, 205, 3631–3638. [Google Scholar] [CrossRef]
- Shirley, D.A. High-resolution X-ray photoemission spectrum of the valence bands of gold. Phys. Rev. B 1972, 5, 4709–4716. [Google Scholar] [CrossRef]
- Srivastava, M.S. Methods of Multivariate Statistics; Wiley-Interscience: New York, NY, USA, 2004; p. 109. [Google Scholar]
- Yu, W.; Ren, G.B.; Wang, S.F.; Han, L.; Li, X.W.; Zhang, L.S.; Fu, G.S. Effect of gas pressure on the synthesis of carbon nitride films during plasma-enhanced chemical vapor deposition. Thin Solid Films 2002, 402, 55–59. [Google Scholar] [CrossRef]
- Zocco, A.; Perrone, A.; Broitman, E.; Czigany, Z.; Hultman, L.; Anderle, M.; Laidani, N. Mechanical and tribological properties of CNx films deposited by reactive pulsed laser ablation. Diam. Relat. Mater. 2002, 11, 98–104. [Google Scholar] [CrossRef]
- Permatasari, F.A.; Aimon, A.H.; Iskandar, F.; Ogi, T.; Okuyama, K. Role of C–N configurations in the photoluminescence of graphene quantum dots synthesized by a hydrothermal route. Sci. Rep. 2016, 6, 21042. [Google Scholar] [CrossRef] [PubMed]
- Chang, Y.Y.; Wang, D.Y.; Wu, W. Catalysis effect of metal doping on wear properties of diamond-like carbon films deposited by a cathodic-arc activated deposition process. Thin Solid Films 2002, 420, 241–247. [Google Scholar] [CrossRef]
- Zheng, Y.; Liu, X.; Zhang, H. Properties of Zr–ZrC–ZrC/DLC gradient films on TiNi alloy by the PIIID technique combined with PECVD. Surf. Coat. Technol. 2008, 202, 3011–3016. [Google Scholar] [CrossRef]
- Xu, J.; Wang, Y.; Shang, J.; Ma, D.; Li, Y. Preparation of mesoporous carbon nitride materials using urea and formaldehyde as precursors and catalytic application as solid bases. Appl. Catal. A Gen. 2017, 538, 221–229. [Google Scholar] [CrossRef]
- Badrinarayanan, S.; Sinha, S.; Mandale, A.B. XPS studies of nitrogen ion implanted zirconium and titanium. J. Electron Spectrosc. Relat. Phemon. 1989, 49, 303–309. [Google Scholar] [CrossRef]
- Anderson, J.A.; Fierro, J.L.G. Bulk and surface properties of copper-containing oxides of the general formula LaZr1-xCuxO3. J. Solid State Chem. 1994, 108, 305–313. [Google Scholar] [CrossRef]
- Galuska, A.A.; Uht, J.C.; Marquez, N. Reactive and nonreactive ion mixing of Ti films on carbon substrates. J. Vac. Sci. Tech. A 1988, 6, 110–122. [Google Scholar] [CrossRef]
- Chourasia, A.R.; Chopra, D.R. X-ray photoelectron spectra of TiN. Surf. Sci. Spectra 1992, 1, 233–237. [Google Scholar] [CrossRef]
- Saied, S.O.; Sullivan, J.L.; Choudhury, T.; Pearce, C.G. A comparison of ion and fast atom beam reduction in TiO2. Vacuum 1988, 38, 917–922. [Google Scholar] [CrossRef]
- Chang, Y.-Y.; Huang, H.-L.; Chen, H.-J.; Lai, C.-H.; Wen, C.-Y. Antibacterial properties and cytocompatibility of tantalum oxide coatings. Surf. Coat. Technol. 2014, 259, 193–198. [Google Scholar] [CrossRef]
- Harris, L.G.; Richards, R.G. Staphylococci and implant surfaces: A review. Injury 2006, 37, S3–S14. [Google Scholar] [CrossRef] [PubMed]
- Van Winkelhoff, A.; Wolf, J. Actinobacillus actinomycetemcomitans-associated peri-implantitis in an edentulous patient. J. Clin. Periodontol. 2000, 27, 531–535. [Google Scholar] [CrossRef] [PubMed]
- Kang, S.; Pinault, M.; Pfefferle, L.D.; Elimelech, M. Single-walled carbon nanotubes exhibit strong antimicrobial activity. Langmuir 2007, 23, 8670–8673. [Google Scholar] [CrossRef] [PubMed]
- Affonso, L.O. Machinery Failure Analysis Handbook—Sustain Your Operations and Maximize Uptime; Gulf Publishing Company: Houston, TX, USA, 2006. [Google Scholar]

| Samples | Composition (at. %) | Coating Thickness (μm) | ||
|---|---|---|---|---|
| Me | C | N | ||
| CNx | - | 68 | 32 | 2.0 |
| CNx-W | 6 | 60 | 34 | 2.1 |
| CNx-Ti | 6 | 58 | 36 | 1.6 |
| CNx-Zr | 7 | 62 | 31 | 1.8 |
| CNx-Cr | 6 | 58 | 36 | 1.9 |
| Samples | Surface Roughness Ra (nm) | Adhesion Lc (N) | ID/IG |
|---|---|---|---|
| CNx | 31 | 68 | 1.49 |
| CNx-W | 12 | 68 | 1.63 |
| CNx-Ti | 10 | 74 | 2.10 |
| CNx-Zr | 17 | 80 | 2.85 |
| CNx-Cr | 18 | 75 | 1.72 |
© 2017 by the authors. Licensee MDPI, Basel, Switzerland. This article is an open access article distributed under the terms and conditions of the Creative Commons Attribution (CC BY) license (http://creativecommons.org/licenses/by/4.0/).
Share and Cite
Yao, S.-H.; Su, Y.-L.; Lai, Y.-C. Antibacterial and Tribological Performance of Carbonitride Coatings Doped with W, Ti, Zr, or Cr Deposited on AISI 316L Stainless Steel. Materials 2017, 10, 1189. https://doi.org/10.3390/ma10101189
Yao S-H, Su Y-L, Lai Y-C. Antibacterial and Tribological Performance of Carbonitride Coatings Doped with W, Ti, Zr, or Cr Deposited on AISI 316L Stainless Steel. Materials. 2017; 10(10):1189. https://doi.org/10.3390/ma10101189
Chicago/Turabian StyleYao, Sun-Hui, Yen-Liang Su, and Yu-Cheng Lai. 2017. "Antibacterial and Tribological Performance of Carbonitride Coatings Doped with W, Ti, Zr, or Cr Deposited on AISI 316L Stainless Steel" Materials 10, no. 10: 1189. https://doi.org/10.3390/ma10101189




